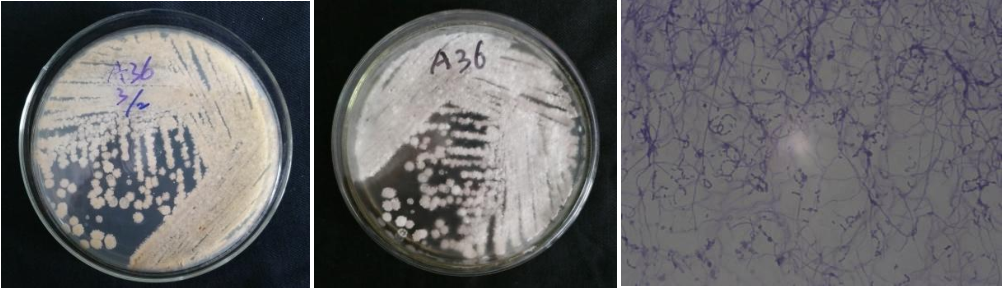

Loading...
| StrainNO | A36 |
| Classification | Streptomyces |
| 16s rDNA sequence | CACACGCAAGTCGAACGATGAACCTCCTTCGGGAGGGGATTAGTGGCGAACGGGTGAGTAACACGTGGGCAATCTGCCCTGCAC TCTGGGACAAGCCCTGGAAACGGGGTCTAATACCGGATACAACCACTGGGGGCATCCTCTGGTGGTGGAAAGCTCCGGCGGTGC AGGATGAGCCCGCGGCCTATCAGCTAGTTGGTGAGGTAATGGCTCACCAAGGCGACGACGGGTAGCCGGCCTGAGAGGGCGACC GGCCACACTGGGACTGAGACACGGCCCAGACTCCTACGGGAGGCAGCAGTGGGGAATATTGCACAATGGGCGAAAGCCTGATGC AGCGACGCCGCGTGAGGGATGACGGCCTTCGGGTTGTAAACCTCTTTCAGCAGGGAAGAAGCGAAAGTGACGGTACCTGCAGAA GAAGCGCCGGCTAACTACGTGCCAGCAGCCGCGGTAATACGTAGGGCGCAAGCGTTGTCCGGAATTATTGGGCGTAAAGAGCTC GTAGGCGGCTTGTCACGTCGGTTGTGAAAGCCCGGGGCTTAACCCCGGGTCTGCAGTCGATACGGGCAGGCTTAGATTCGGTAG GGAGATCGGAATTCCTTGTGTAGCGGTGAAATGCGCAAAAT TCTGGGACAAGCCCTGGAAACGGGGTCTAATACCGGATACAACCACTGGGGGCATCCTCTGGTGGTGGAAAGCTCCGGCGGTGC AGGATGAGCCCGCGGCCTATCAGCTAGTTGGTGAGGTAATGGCTCACCAAGGCGACGACGGGTAGCCGGCCTGAGAGGGCGACC GGCCACACTGGGACTGAGACACGGCCCAGACTCCTACGGGAGGCAGCAGTGGGGAATATTGCACAATGGGCGAAAGCCTGATGC AGCGACGCCGCGTGAGGGATGACGGCCTTCGGGTTGTAAACCTCTTTCAGCAGGGAAGAAGCGAAAGTGACGGTACCTGCAGAA GAAGCGCCGGCTAACTACGTGCCAGCAGCCGCGGTAATACGTAGGGCGCAAGCGTTGTCCGGAATTATTGGGCGTAAAGAGCTC GTAGGCGGCTTGTCACGTCGGTTGTGAAAGCCCGGGGCTTAACCCCGGGTCTGCAGTCGATACGGGCAGGCTTAGATTCGGTAG GGAGATCGGAATTCCTTGTGTAGCGGTGAAATGCGCAAAAT |
| Strain Morphology Photos | |
| Morphological Description | hyphae branch;flourish;protoplast condensed;vacuole;hyphae bundled and many;spore chain short;old mycelium vacuoles in clusters;spore pile gray and powdery;back soil yellow |